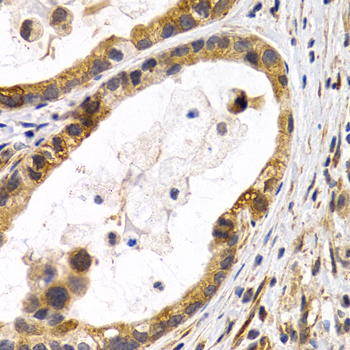
A2514: image 7

For quotations, please use our online quotation form, and you may also contact us by
sales@neoscientific.com
+1-888.733.6849
+1-617.299.7367 (Int’l)
+1-888.733.6849
+1-617.299.7367 (Int’l)
| Reactivity | Human Mouse Rat |
| Tested applications | WB IHC IF |
| Recommended Dilution | WB 1:500 - 1:2000 IHC 1:50 - 1:200 IF 1:50 - 1:100 |
| Calculated MW | 22kDa |
| Observed MW | Refer to figures |
| Immunogen | Recombinant protein of human HSPB8 |
| Storage Buffer | Store at -20℃. Avoid freeze / thaw cycles. Buffer: PBS with 0.02% sodium azide, 50% glycerol, pH7.3. |
| Synonym | H11; HMN2; CMT2L; DHMN2; E2IG1; HMN2A; HSP22; |

Western blot analysis of extracts of BT474 cells, using HSPB8 antibody.

Immunohistochemistry of paraffin-embedded rat lung using HSPB8 antibody at dilution of 1:200 (400x lens).

Immunohistochemistry of paraffin-embedded rat pancreas using HSPB8 antibody at dilution of 1:200 (400x lens).

Immunohistochemistry of paraffin-embedded human thyroid cancer using HSPB8 antibody at dilution of 1:200 (400x lens).

Immunohistochemistry of paraffin-embedded human normal colon using HSPB8 antibody at dilution of 1:200 (400x lens).

Immunohistochemistry of paraffin-embedded human colon cancer using HSPB8 antibody at dilution of 1:200 (400x lens).
Immunohistochemistry of paraffin-embedded human lung cancer using HSPB8 antibody at dilution of 1:200 (400x lens).

Immunohistochemistry of paraffin-embedded human stomach cancer using HSPB8 antibody at dilution of 1:200 (400x lens).

Immunofluorescence analysis of HeLa cell using HSPB8 antibody. Blue: DAPI for nuclear staining.
The protein encoded by this gene belongs to the superfamily of small heat-shock proteins containing a conservative alpha-crystallin domain at the C-terminal part of the molecule. The expression of this gene in induced by estrogen in estrogen receptor-positive breast cancer cells, and this protein also functions as a chaperone in association with Bag3, a stimulator of macroautophagy. Thus, this gene appears to be involved in regulation of cell proliferation, apoptosis, and carcinogenesis, and mutations in this gene have been associated with different neuromuscular diseases, including Charcot-Marie-Tooth disease.
N/A